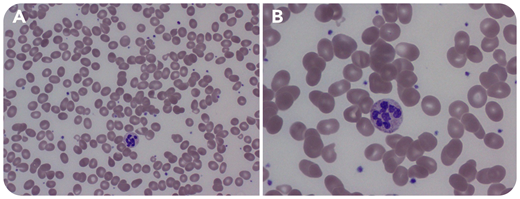
A 39-year-old woman developed paresthesia and macrocytic anemia (hemoglobin, 9.9 g/dL; reference range, 12-16 and mean corpuscular volume, 113 fL; reference range, 80-100). Cyanocobalamin (B12) deficiency was strongly suspected; surprisingly, the initial B12 level returned elevated at 1328 pg/mL (reference range, 180-914). A Romanowsky-stained peripheral smear was obtained (panel A: original magnification ×500; panel B: original magnification ×1000) showing anisopoikilocytosis, oval macrocytes, and hypersegmented neutrophils with >5 lobes. Methylmalonic acid (MMA) and homocysteine were elevated. B12 is required as a cofactor for the conversion of homocysteine to methionine and MMA to succinyl–coenzyme A, thus leading to elevated levels of both with B12 deficiency. The B12 level on a different analyzer returned low at 65 pg/mL (reference range, 301-1100). Intrinsic factor antibodies (IFAs) were strongly positive. She was diagnosed with pernicious anemia and given B12 replacement, with complete resolution of her neurologic symptoms and anemia.

A 39-year-old woman developed paresthesia and macrocytic anemia (hemoglobin, 9.9 g/dL; reference range, 12-16 and mean corpuscular volume, 113 fL; reference range, 80-100). Cyanocobalamin (B12) deficiency was strongly suspected; surprisingly, the initial B12 level returned elevated at 1328 pg/mL (reference range, 180-914). A Romanowsky-stained peripheral smear was obtained (panel A: original magnification ×500; panel B: original magnification ×1000) showing anisopoikilocytosis, oval macrocytes, and hypersegmented neutrophils with >5 lobes. Methylmalonic acid (MMA) and homocysteine were elevated. B12 is required as a cofactor for the conversion of homocysteine to methionine and MMA to succinyl–coenzyme A, thus leading to elevated levels of both with B12 deficiency. The B12 level on a different analyzer returned low at 65 pg/mL (reference range, 301-1100). Intrinsic factor antibodies (IFAs) were strongly positive. She was diagnosed with pernicious anemia and given B12 replacement, with complete resolution of her neurologic symptoms and anemia.
At presentation, she had classic findings for B12 deficiency, apart from the elevated B12 level. Extremely high-titer IFAs have been reported to cause in vitro interference by binding the test reagent, leading to falsely normal or even high B12 levels. In the second laboratory, a dilution process was used to decrease that interference. Clinical suspicion, evaluation of the peripheral smear, and further testing were essential in making this important diagnosis. Without proper treatment, neurologic symptoms would have progressed.
A 39-year-old woman developed paresthesia and macrocytic anemia (hemoglobin, 9.9 g/dL; reference range, 12-16 and mean corpuscular volume, 113 fL; reference range, 80-100). Cyanocobalamin (B12) deficiency was strongly suspected; surprisingly, the initial B12 level returned elevated at 1328 pg/mL (reference range, 180-914). A Romanowsky-stained peripheral smear was obtained (panel A: original magnification ×500; panel B: original magnification ×1000) showing anisopoikilocytosis, oval macrocytes, and hypersegmented neutrophils with >5 lobes. Methylmalonic acid (MMA) and homocysteine were elevated. B12 is required as a cofactor for the conversion of homocysteine to methionine and MMA to succinyl–coenzyme A, thus leading to elevated levels of both with B12 deficiency. The B12 level on a different analyzer returned low at 65 pg/mL (reference range, 301-1100). Intrinsic factor antibodies (IFAs) were strongly positive. She was diagnosed with pernicious anemia and given B12 replacement, with complete resolution of her neurologic symptoms and anemia.
At presentation, she had classic findings for B12 deficiency, apart from the elevated B12 level. Extremely high-titer IFAs have been reported to cause in vitro interference by binding the test reagent, leading to falsely normal or even high B12 levels. In the second laboratory, a dilution process was used to decrease that interference. Clinical suspicion, evaluation of the peripheral smear, and further testing were essential in making this important diagnosis. Without proper treatment, neurologic symptoms would have progressed.
For additional images, visit the ASH Image Bank, a reference and teaching tool that is continually updated with new atlas and case study images. For more information, visit http://imagebank.hematology.org.
This feature is available to Subscribers Only
Sign In or Create an Account Close Modal